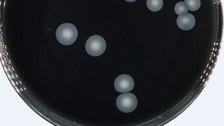
Ziebart

Controlling and monitoring bioprocesses
The SmartLab Systems core research area at the Institute of Natural Materials Technology deals with topics relating to Industry 4.0, the Internet of Things and Big Data in the laboratory environment and biotechnology in general.
In addition to the next generation of autonomous mobile sensor systems, work focuses on computer vision on biological samples and their manipulation as well as many issues relating to laboratory automation.
analytica 2020: Forum Digital Transformation - Collaborate2Lab © analytica

© Ziebart

© Ziebart

© Ziebart

© Ziebart

© Ziebart

© Ziebart

© Ziebart

© Ziebart

© Ziebart

© Ziebart

© Ziebart

© Ziebart

© Ziebart

© Ziebart

© Ziebart

© Ziebart

© Ziebart

© Ziebart

© Ziebart

© Ziebart

© Ziebart

© Ziebart

© Ziebart
Projects of the SmartLab Systems research group:
- TitraBot
- autoLAMPe (autonomous drinking water monitoring using loop mediated amplification for real-time monitoring)
- FISCH platform: Functionalized Integrated Sensor Connector Housing platform
- PriMuS-Bioreactor-Printed-Multiparameter-Sensor-Bioreactor
- smartFormulation- Development of an automated, functionally integrated system for the production and quality assessment of insoluble mixed compounds in pharmaceuticals, biotechnology and cosmetics, as well as the determination and recording of process-related parameters.
- SmartAQAlab - Development of a semi-automated assistance system for the multiparametric analysis of drinking and process water
- dOxy2SensE - Dissolved-O2 Sens-o-Spheres Expansion
- LiquiPlate - Development, construction and testing of an automated system for concentrating and plating liquid samples in culture dishes with automatic incubation and inspection
- SteriBot - Development of an automation system for the sterility testing of radiopharmaceuticals
- iPhoto - Development and testing of an automatic photo station for recording, documenting and measuring laboratory samples and connection to a LIMS
Employees of BVT in the field of SmartLab systems:

Project researcher
NameMr Ayur Ghalot M. Eng.
SmartLab-Systems, Sensor development
Send encrypted email via the SecureMail portal (for TUD external users only).
Certificate of DFN-PKI for encrypted email communication.
 © blend3
© blend3
Project researcher
NameDipl.-Ing. Alexander Gießel
SmartLab-systems, sensor development
Send encrypted email via the SecureMail portal (for TUD external users only).
 © blend3
© blend3
External PhD student
NameDipl.-Ing. Mickey Hawelitschek
SmartLab-systems, assistance systems
Send encrypted email via the SecureMail portal (for TUD external users only).
 © Mann
© Mann
Project researcher
NameDr.-Ing. Tim Lauterbach
SmartLab-systems, sensor development
Send encrypted email via the SecureMail portal (for TUD external users only).

Project researcher
NameMr Dr. rer. nat. Gregor Michl
SmartLab-Systems, Sensor development
Send encrypted email via the SecureMail portal (for TUD external users only).
 © Mann
© Mann
Project researcher
NameDipl.-Ing. Christoph Otto
SmartLab-systems, lab automation
Send encrypted email via the SecureMail portal (for TUD external users only).

Project researcher
NameMs Saniya Ustun M. Sc.
SmartLab-Systems, Lab automation
Send encrypted email via the SecureMail portal (for TUD external users only).
Multimedia:
Live demo Flowlab at ACHEMA pulse 2021
Webinar collection analytica virtual 2020 - Forum Digital Transformation
Video article on bioökonomie.de: Mini measuring spheres for bioreactors
Engagement:
OPC UA LADS - Laboratory & Analytical Device Standard